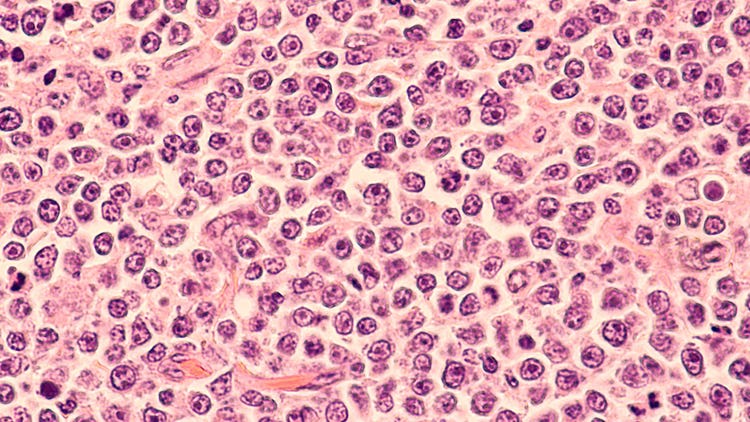

B Cell: Plasma and Memory Types
B cells are white blood cells that are vital in producing antibodies. Each B cell can produce a unique antibody molecule, which can bind specifically to one type of antigen. This is achieved through somatic hypermutation, class switching or V(D)J recombination, where different gene segments encoding the antibody molecule are rearranged to create a unique combination.
When an antigen enters the body, it is taken up by specialized immune cells and presented to B cells. B cells will bind to the antigen, triggering events that lead to their activation and proliferation. Once activated, B cells undergo a process known as clonal expansion, where they divide rapidly to produce many identical copies.
These activated B cells then differentiate into two main types: plasma and memory B cells. Plasma cells release significant quantities of antibody molecules into the bloodstream to neutralize an antigen. Memory B cells are long-lived cells that "remember" the specific antigen and can quickly produce many antibodies upon re-exposure.
Antibody Generation using Single B Cell Technology
Generating antibodies using single B cells offers several advantages over traditional antibody production methods, including reduced animal use, cost and improved reproducibility. Researchers can isolate individual B cells from the blood or tissue to produce antibodies from single B cells. The antigen of interest can then activate these B cells to produce the desired antibodies.
After identifying a B cell that produces the desired antibody, its genetic material can be sequenced to determine the exact sequence of the antibody molecule. The antibody sequence can then be cloned into cell lines to produce large quantities of the antibody using recombinant DNA technology. Alternatively, the activated B cell can be fused with a cancer cell to create a hybridoma or immortalized using viral vectors to produce the antibody continuously.
B Cell Antibody Production
Protocols for generating antibodies from single B cells vary based on platform and maturity but typically involve the following steps:
- Isolation of single B cells: B cells can be obtained from various sources, including the blood or tissue of an organism. Single B cells can be isolated using fluorescence-activated cell sorting (FACS) or magnetic-activated cell sorting (MACS).
- Stimulation of B cells: Once single B cells have been isolated, they are stimulated with the antigen of interest to activate them and induce antibody production. This can be done using various methods, including exposing the cells to the antigen in vitro or injecting the antigen into the animal from which the B cells were obtained.
- Screening for antibody production: After B cells have been stimulated, they are screened for the desired antibody. This can be done using techniques such as ELISA or Western blotting, which detect the presence of the antibody in the culture medium or on a membrane, respectively.
- Cloning of B cells: Once a B cell that produces the desired antibody has been identified, it can be cloned to produce many identical copies. This is typically done using polymerase chain reaction (PCR) to amplify the DNA encoding the antibody molecule, followed by inserting that sequence into a vector.
- Expression and purification of antibodies: The cloned DNA can express the antibody in immortalized B cells, bacteria, yeast or mammalian cells. The expressed antibody is then purified using techniques such as chromatography to remove impurities and isolate the antibody of interest.
- Characterization of antibodies: The purified antibody can be characterized using binding assays to determine its specificity and affinity and functional assays to determine its ability to neutralize the antigen or activate immune cells.
See how Danaher Life Sciences can help
Advantages of B Cell Antibody Production
Generating antibodies using single B cells offers several advantages over traditional antibody production methods. Here are some of the key benefits:
- Increased specificity: Single B cell-based approaches allow for isolating individual B cells that produce antibodies with high specificity and affinity for the target antigen. This can result in highly effective antibodies that neutralize the target and have minimal off-target effects.
- Diverse antibody repertoire: Each B cell has the potential to produce a unique antibody molecule, meaning that single B cell-based approaches can generate a diverse array of antibodies that target different epitopes on the antigen.
- Reduced animal use: Single B cell-based approaches typically require fewer animals than traditional methods, as each animal can provide many B cells that can be screened and cloned to produce multiple antibodies. This can reduce the number of animals needed for antibody production, an important ethical consideration.
- Reduced time and cost: Single B cell-based approaches can be faster and more cost-effective than traditional antibody production methods, as they often require fewer steps and have a higher success rate in generating effective antibodies.
- Improved reproducibility: Single B cell-based approaches offer greater reproducibility than traditional methods, as each B cell can be tracked, and its antibody production can be monitored throughout the process. This can help ensure that the final product is consistent and meets quality standards.
Future of B Cell Antibody Production
The future of generating antibodies using single B cells is promising, with ongoing advancements likely to lead to new and innovative applications. Here are some of the key areas where single B cell-based approaches are likely to have a significant impact in the coming years:
- Personalized medicine: Single B cell-based approaches offer the potential to generate highly personalized antibody therapies tailored to the individual patient's needs. By isolating B cells from an individual's immune system, it may be possible to produce antibodies that are better tolerated and have greater efficacy than traditional antibody therapies.
- Targeting complex antigens: Single B cell-based approaches are well-suited to developing antibodies that target complex antigens, such as membrane proteins or highly conserved regions of viruses. By isolating B cells that produce antibodies with high specificity and affinity for these targets, it may be possible to develop highly effective therapies for various diseases.
- Improved cell culture techniques: Advances in media formulations and cell culture systems could lengthen the lifecycle for high-producing single B cells. Platforms with integrated quality control mechanisms to monitor conditions, screen for output and allow for real-time adjustments will give antibody developers more control over the entire process.
- Machine learning/Artificial intelligence: Single B cell-based approaches increasingly employ machine learning and artificial intelligence to enable faster and more efficient antibody discovery and development. These technologies can accelerate the pace of innovation in the field and lead to breakthroughs.
See how Danaher Life Sciences can help
B Cell Antibody Production